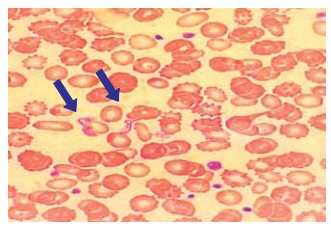
Enunciado 4449132-1

A figura a seguir apresenta um esfregaço de sangue
venoso, em que são visíveis formas características de
um protozoário flagelado. Esse parasita é transmitido por
insetos triatomíneos e está associado a uma doença tropical de grande impacto na América Latina.
 (Arquivo pessoal; imagem usada com autorização)
(Arquivo pessoal; imagem usada com autorização)
Qual é a doença representada na figura?
(Arquivo pessoal; imagem usada com autorização)
(Arquivo pessoal; imagem usada com autorização) Qual é a doença representada na figura?
Provas
Questão presente nas seguintes provas
Médico - Patologia Clínica/Medicina Laboratorial
50 Questões